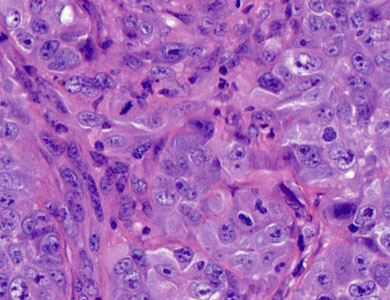
Timm染色

TTC染色
TTC染色是TTC和活细胞线粒体内的琥珀酸脱氢酶反应,生成红色的甲臜,用来表示细胞的活力。配制多为2%,染色要避光,37度条件下,它是评价脑缺血损伤常用的指标。 TTC染色 1原理:TTC(2,3,5—氯化三苯基四氮唑)是脂溶性光敏感复合物,1894年*合成用来检测种子的生存能力
地区:上海服务名称:TTC染色
询价

OEM组件-显微镜设备集成解决方案
我们的光学器件成为了全球各类科学成像和分析产品的骨干。开发创新型生命科学和工业仪器的诸多企业正是因为我们的丰富经验、质量声誉以及帮助他们为客户提供高品质产品的承诺而信赖奥林巴斯。请相信我们的专家能够帮助您的设计人员将奥林巴斯组件集成到您的设备之中。 开发到制造的技术支持 我们的技
询价

免疫组化阅片评分
产品名称:免疫组化阅片评分 产品说明: 各种种属样本的免疫组化/荧光分析阅片分析。Pilot实验专属病理专家咨询、阅片讨论。 常规指标为免疫组化IRS评分,对免疫组化切片中的染色程度(0-3分)以及阳性率(0-4分)分别评分后相乘得到综合评分(0-12分)。具体如下,染色强度以目的
地区:全国服务名称:免疫组化阅片评分
询价

激光共聚焦病理检测服务
品牌 其他品牌 产地类别 国产 应用领域 医疗卫生,生物产业,综合 激光共聚焦病理检测服务:激光扫描共聚焦显微镜(Confocal laser scanning microscope,简称CLSM)是近代生物医学图象仪器。它是在荧光显微镜成象的基础上加装激光扫描装置,使用紫外光或
地区:上海服务名称:激光共聚焦病理检测服务

银染法染色
银染法染色 一、定义与原理 定义:银染是一种通过化学反应使银离子在蛋白质上沉积形成可见的银颗粒,从而实现对蛋白质进行染色的技术。 原理:在碱性条件下,甲醛等还原剂可以将蛋白带上的xiaosuanyin(银离子)还原成金属银,这些金属银颗粒沉积在蛋白质上,形成可见的染色效果。

冰冻切片检测
,当盒底部接触液氮时即开始气化沸腾,此时小盒保持原位切勿浸入液氮中,大约10-20s 组织即迅速冰结成块。在制成冻块后,即可置入恒冷箱切片机冰冻切片。若需要保存,应快速以铝箔或塑料薄膜封包,立即置入-80°C冰箱贮存备用。 3.固定:样品托上涂一层OCT包埋胶,将速冻组织置于其上,

多重荧光免疫组化(mIHC)
组织芯片多色是公司的主打实验服务项目,公司优势1、自建了组织芯片库,芯片及资料信息完备,现货。2、多色实验自己的检测平台,不需要外包,还可以参观实验,售后无忧! 实验采用TSA体系,酪酰胺信号放大(TSA,Tyramide dignal amplification)技术是一类利用辣
文献支持服务名称:多重荧光免疫组化提供商:上海威奥生物
询价

苏丹III染色
脂肪呈小滴状悬浮于细胞质内,比较显著的如肝细胞。脂肪小滴可以集合,将细胞质及细胞核挤到一旁,如脂肪细胞。如果组织中脂肪过多,将会影响其正常功能,如脂肪肝。 脂肪不溶于水,易溶于浓乙醇、苯、氯仿等,因此制作脂类标本一般不用石蜡切片,而用冰冻切片或者铺片法以保存脂类,固定多用甲醛类固定
地区:全国服务名称:苏丹III染色

激光共聚焦拍片/免疫荧光拍片
以用于活体细胞或组织功能的实时动态监测。该技术成为形态学、分子细胞生物学、神经科学、药理学和遗传学等领域中新的有力研究工具。 服务项目 收费标准 标本要求 备注 白光拍片 10元/照片 染好的切片 拍照请明确拍照部位及拍照倍数,默认一张 免疫荧光拍片 20元/照片 染好的切片 激光
地区:上海服务名称:激光共聚焦拍片/免疫荧光拍片

冰冻包埋
是一种在低温条件下使组织快速冷却到一定硬度,然后进行切片的方法。因其制作过程较石蜡切片快捷、简便,而多应用于手术中的快速病理诊断。冰冻切片的种类较多,有低温恒冷箱冰冻切片法,二氧化碳冰冻切片法,甲醇循环制冷冰冻切片法等。 操作步骤 取材,未能固定的组织取材,不能太大太厚,厚者冰冻
询价
Timm染色
服务介绍 Timm染色 Timm染色方法是一种能够显示组织细胞内重金属分布的常用方法。苔藓纤维末端是脑内含锌量最高的区域,因此可以用此方法显示苔藓纤维末梢分布的情况。其原理是对离子状态、 疏松结合或螯合状态下的锌离子染色,便于光、电镜的观察。 服务内容 1.切片贴附于多聚赖氨酸处
地区:上海提供商:赛戈(上海)生物科技有限公司
询价

特殊包埋
猫 部分显露肌梭包埋为例 固定 将取出的肌肉置于含 5% 戊er醛的 0.1mol/l 二甲SHEN酸Na缓冲液内,PH 值为 7.2, 原位固定 5 min(戊er醛常由 25% 溶液 稀释而成。因其易聚合,所以使用之前应保存于 4℃ 以下)。 将肌纤维切成 10 mm 长,以
地区:浙江省服务名称:特殊包埋

EVG染色实验
EVG染色实验服务 产品介绍: 弹力纤维Verhoeff’s Van Gieson (EVG)染色,弹性纤维广泛分布与身体各处,特别在动脉壁、肺泡壁和皮肤中最为丰富。观察组织内弹性纤维是否有增生或断裂崩解等。组织被含有三氯化铁和碘的苏木精染色再用过量的媒染剂三氯化铁中断组织与染料
地区:上海 服务名称:EVG染色实验服务

病理图像分析系统 AP-TIME 软件功能
病理图像分析系统 AP-TIME 软件功能配置介绍 标准版 AP-TIME 的功能配置包括 1、4 项 AI 模块: ①明场 IHC 图像细胞自动识别; ②荧光图像细胞自动识别; ③肿瘤与间质的自动化区域分割; ④三级淋巴结构 TLS 自动化识别)。 2、7 大功能模块分析: ①
服务名称:病理图像提供商:古朵生物
询价

病理级免洗载玻片
病理级免洗载玻片 产品货号:SS8002 产品描述 厚度1.0-1.2mm,尺寸:25mm×75mm 浮法玻璃材质 品质超白;油漆彩涂 四面磨边,八面倒角 包装50片/盒,50盒/箱 产品特点 表面清洁,干燥 亲水,显中性 产品用途 普通病理制片 粘附载玻片制片
地区:上海服务名称:病理级免洗载玻片
询价

激光捕获显微切割
LCM:激光捕获显微切割(LASER CAPTURE MICRODISSECTION); 原理介绍:在激光脉冲形成的能量差作用下,组织边缘被切断分离,在红外激光作用下瞬间熔化组织并粘附靶标,将靶标吸附在特定的收集帽上。 应用介绍:在高分辨率显微镜放大后可在明场、荧光场条件下对影像
服务名称:显微切割
询价

马松三色染色服务
马松三色 一、病理学实验服务 病理学研究主要是将部分有病变的组织或脏器经过各种化学品和埋藏法的处理,使之固定硬化,在切片机上切成薄片,粘附在玻片上,染以各种颜色,供在显微镜下检查,以观察病理变化,作出病理诊断,为临床诊断和治疗提供帮助。 二、软拓生物免疫组化服务 masson染色
询价














